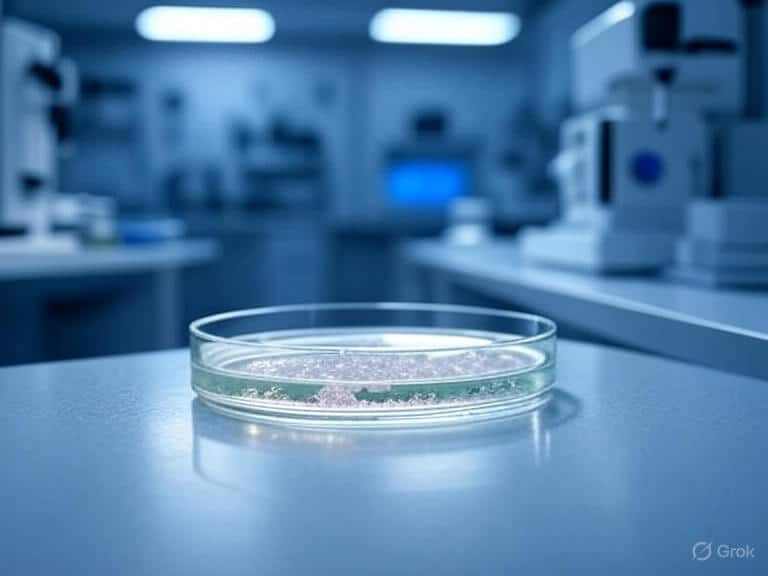

Folks, hold onto your hats because Vor Biopharma (NASDAQ: VOR) is making waves in the market today, August 13, 2025, and for good reason! As of this writing, the stock is up a jaw-dropping 25% in pre-market trading, riding high on news that could shake up the world of autoimmune disease treatments. The catalyst? Their collaborator, RemeGen, just dropped a bombshell: telitacicept, a drug Vor’s betting big on, nailed its primary endpoint in a Phase 3 clinical study for primary Sjögren’s disease in China. This is huge, and it’s got investors buzzing like bees around a honeycomb. Let’s break it down, talk about what this means for traders, and weigh the risks and rewards of jumping into a stock like VOR. Plus, if you’re into staying ahead of the market’s wild swings, you can get free daily stock alerts sent straight to your phone by tapping here.
What’s Driving the Surge?
So, what’s got everyone so excited? Telitacicept, a dual BAFF/APRIL inhibitor, just showed it can reduce disease activity in primary Sjögren’s disease, a chronic autoimmune condition that’s been a tough nut to crack. The study, run by RemeGen in China, hit its primary endpoint by improving the EULAR Sjögren’s Syndrome Disease Activity Index (ESSDAI), which measures how severe the disease is across 12 different domains. In plain English, this drug seems to calm down the overactive immune system that wreaks havoc on patients’ moisture-producing glands and other organs. Even better, it showed a “favorable safety profile,” meaning it didn’t raise any major red flags in terms of side effects. That’s the kind of news that makes Wall Street sit up and take notice.
Sjögren’s disease isn’t just a niche problem—it’s one of the most common rheumatic autoimmune diseases out there, affecting mostly women and often going undiagnosed. It causes dry eyes, dry mouth, fatigue, pain, and sometimes serious complications like lung or kidney issues, even raising the risk of lymphoma. Right now, there’s no real game-changer for treating it; doctors mostly focus on managing symptoms, which doesn’t always cut it. If telitacicept can step up as a “best-in-disease” treatment, as Vor’s CEO Jean-Paul Kress is suggesting, it could be a blockbuster in the making.
Why This Matters for Traders
Let’s talk trading, because that’s where the rubber meets the road. As of this writing, VOR’s stock price is hovering around $2.12 in pre-market trading, a big jump from yesterday’s close of $1.66. That kind of move screams opportunity, but it also comes with a side of caution. Biotech stocks like Vor are notorious for their volatility—when they pop, they can soar, but when they drop, it’s like a bungee jump without the cord. The news about telitacicept is a classic catalyst: positive clinical trial results often send biotech stocks skyrocketing, especially for a company like Vor, which is still in the clinical-stage and doesn’t have revenue from product sales yet.
The market’s reaction today shows how much investors love a good story. Posts on X are buzzing with excitement, with some calling this a “star” moment for Vor. But here’s the thing: trading on news like this is a double-edged sword. The 25% pre-market surge is thrilling, but it’s not guaranteed to hold through the day. Momentum traders might pile in, hoping to ride the wave, while others might wait for a pullback, knowing that biotech stocks can swing wildly after big announcements. If you’re thinking about jumping in, keep an eye on the volume—yesterday’s trading saw 1.95 million shares change hands, and today’s pre-market action suggests even more action. High volume can fuel bigger moves, but it can also mean bigger drops if the hype fades.
Want to stay on top of these kinds of market movers? You can get free daily stock alerts sent to your phone to keep you in the loop on hot stocks and market trends. Just tap here to sign up.
The Big Picture: Risks and Rewards
Let’s get real about the risks. Biotech investing is not for the faint of heart. Vor’s market cap is around $261 million, which is small potatoes in the grand scheme of things. That means even small bits of news can send the stock soaring or crashing. Right now, Vor has no revenue—zero, zilch—because it’s still in the clinical stage, focused on developing telitacicept for autoimmune diseases like Sjögren’s and myasthenia gravis. That’s a risky bet, because if future trials flop or regulators don’t give the green light, the stock could take a nosedive. The company’s burning cash, too, with a net loss of $32.49 million in the first quarter of 2025 alone.
On the flip side, the rewards could be massive. Telitacicept isn’t just a one-trick pony—it’s already approved in China for systemic lupus erythematosus, rheumatoid arthritis, and myasthenia gravis, and Vor’s running a global Phase 3 trial for myasthenia gravis that could open doors in the U.S., Europe, and Japan. Analysts are bullish, with a consensus price target of $5.63, suggesting a potential 171.91% upside from the August 8 closing price of $2.07. Some are even more optimistic, with high-end targets reaching $14.00. If telitacicept becomes a go-to treatment for Sjögren’s and other autoimmune diseases, Vor could be sitting on a gold mine.
But here’s the kicker: the road to approval is long and bumpy. RemeGen’s planning to submit a Biologics License Application in China, but Vor’s still figuring out the timing for a global Phase 3 study for Sjögren’s. That means more waiting, more cash burn, and more uncertainty. Plus, the biotech sector is crowded, and Vor’s got to compete with big players who have deeper pockets and more established drugs.
What’s Next for Vor?
The next big thing to watch is the full data drop at an upcoming medical conference. That’s when we’ll get the nitty-gritty details on how well telitacicept performed and what it means for patients. If the data’s as good as the press release suggests, it could keep the momentum going. Vor’s also got its eye on expanding telitacicept’s reach beyond Sjögren’s, with myasthenia gravis as its lead indication. That’s a smart move—having a “pipeline-in-a-product” means they’re not putting all their eggs in one basket.
For traders, the short-term action is all about sentiment. The buzz on X shows investors are pumped, but sentiment can flip fast. Long-term, it’s about execution—can Vor and RemeGen turn these trial results into approved drugs and real revenue? Analysts think so, with a “Moderate Buy” rating based on 10 opinions, including 6 buys and 4 holds. But nothing’s guaranteed in biotech land.
Trading Lessons from Today’s Move
This kind of stock pop is a perfect lesson in market dynamics. Big news like a Phase 3 success can light a fire under a stock, but it’s not just about the headline. You’ve got to dig into the details—how strong is the data? What’s the competition like? Is the company’s balance sheet solid enough to keep the lights on? Vor’s got a compelling story, but it’s also got risks that could trip it up. Traders who thrive in this game know how to balance the hype with the hard facts. If you want to stay sharp and catch these opportunities early, sign up for free daily stock alerts to get tips and updates delivered right to your phone. Tap here to join.
Final Thoughts
Vor Biopharma’s making a splash today, and it’s easy to see why. Telitacicept’s success in Sjögren’s disease is a big deal, potentially positioning Vor as a leader in autoimmune treatments. But with great potential comes great risk—biotech stocks are a rollercoaster, and Vor’s no exception. As of this writing, the stock’s riding high, but whether it holds or fades depends on the market’s mood and the data to come. Keep your eyes peeled, do your homework, and if you want to stay in the know, grab those free daily stock alerts by tapping here. The market’s always got surprises up its sleeve, and you don’t want to miss the next one!
 https://www.profitablecpmrate.com/nsirjwzb79?key=c706907e420c1171a8852e02ab2e6ea4
Skip to content
https://www.profitablecpmrate.com/nsirjwzb79?key=c706907e420c1171a8852e02ab2e6ea4
Skip to content